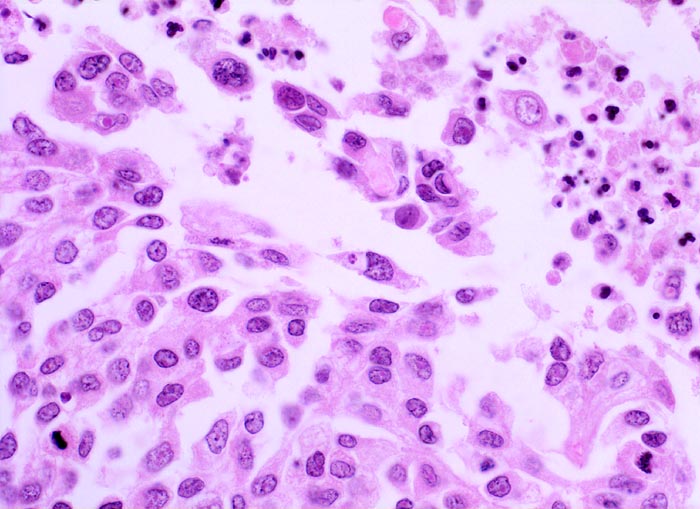

PathoPic – image database / PathoPic ID 4877 - Urothelkarzinom
de
Diagnose
Urothelkarzinom
Diagnose Gruppe
maligner Tumor
Topographie
Harnblase
Topographie Gruppe
Niere, Harnwege
Beschreibung
Lockerer solider Zellverband von zytoplasmareichen stark polymorphen Zellen mit Mitosen. Die Zellkerne sind teilweise gekerbt (typisch für Urothelzellen), die Kernmembranen sind unregelmässig und das Chromatin ist grob gekörnt. Stark vergrösserte Nukleolen. Fokale Nekrose durchsetzt von Granulozyten.
Klinik
Makrohämaturie. In der Harnblasenspülflüssigkeit werden Urothelien mit schweren Kernatypien vereinbar mit Urothelkarzinom nachgewiesen. Zystoskopisch kommt in der Hinterwand ein ulzerierter Tumor zur Darstellung. Die bioptische Abklärung ergibt Anteile eines wenig differenzierten Urothelkarzinoms mit ausgedehnten Nekrosen.
Kommentar
Gelegentlich enthalten kleine Biopsien aus einem Tumor lediglich nekrotische Tumoranteile. In solchen Fällen kann meist keine sichere Diagnose gestellt werden, da unter anderem die Kernbeurteilung als wichtiges Malignitätskriterium bei epithelialen Tumoren nicht möglich ist.
Bilder Typ
Histologie
Vergrösserung
400
Alter
81
Geschlecht
männlich
Datum
Ersteintrag: 11.06.2002
Update: 04.02.2024